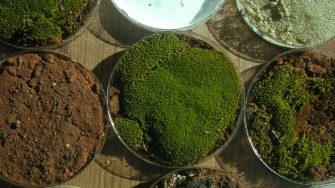
Soil samples

Synopsis
Biological soil crusts (biocrusts) are communities of mosses, lichens liverworts and other microscopic organisms that cover the surface of soils worldwide. Biocrusts are critically important for cycling nutrients, providing habitat for soil animals, and stabilising the soil surface, and are often used as indicators of healthy surfaces.
However, biocrusts are susceptible to disturbance, for example, by livestock trampling or by native animals such as echidnas when they forage for food. Knowing how much disturbance these communities can tolerate is critical if we are to manage these organisms sustainably.
This study will identify the relative importance of intensity and frequency of disturbance on biocrust communities using a combination of fieldwork, glasshouse experiments, and laboratory work. We will impose different levels of disturbance intensity, at different frequencies, and use a resilience index to access the extent to which these communities can recover after various levels of disturbance.
Aims
The aims of this project are to:
- Examine the relative importance of disturbance intensity and frequency on resilience.
- Identify potential thresholds in soil functions that can be linked to changes in the intensity and frequency of disturbances.
- Identify the importance of biocrusts for sustainable soils.
- Link changes in shrub distribution to potential differences in plant traits.
Student benefits
This is a multi-disciplinary project that will expose you to a diverse range of skills. During this project, you will have the opportunity to:
- Work on a project that has strong implications for conservation.
- Experience the problems associated with managing biocrusts to maintain stable functional soils.
- Experience a mixture of fieldwork, data collection and analyses.
- Learn new skills in identifying mosses and lichens.
- Gain exposure to the activities of the NSW National Parks and Wildlife Service.
